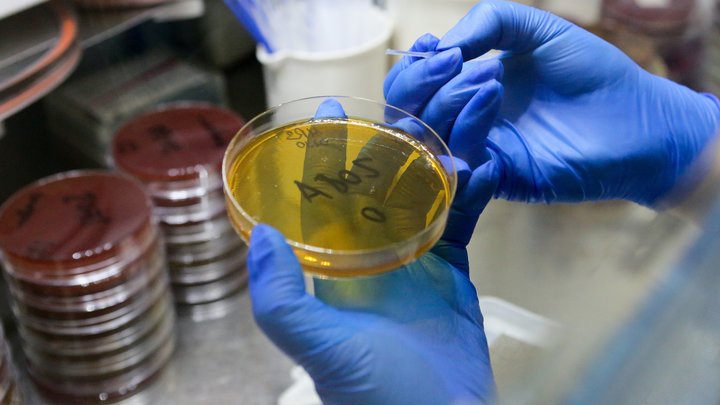
Доктор Розенберг рассказал, как учёные научились отключать раковые опухоли

Доктор Розенберг рассказал, как учёные научились "отключать" раковые опухоли
Доктор Виктор Розенберг рассказал в своём телеграм-канале, как учёные научились "отключать" раковые опухоли. Медик отметил, что, помимо печальных данных о распространении коронавируса, "есть в медицине и хорошие новости".
Эксперт пояснил, что опухоль растёт, получая питательные вещества и кислород из кровеносных сосудов. Однако, если перекрыть этот "кран", рак будет обезврежен.
Розенберг рассказал о методике специалистов из Национальных институтов здравоохранения США. Она предполагает предотвращение прорастания новых кровеносных сосудов, которые необходимы для питания опухоли.
"Идея заключается в блокировании ключевых ферментов, которые, собственно, обеспечивают ангиогенез. В пилотных экспериментах, проведённых на эмбрионах рыбки данио, исследователям уже удалось успешно "отключить" гены, ответственные за выработку этих ферментов", - отметил врач.
По его словам, опыты на мышах также показали уменьшение роста кровеносных сосудов в опухоли.
"Хорошо, что есть и хорошие новости в медицине, кроме печальных - о коронавирусе", - добавил медик.
В феврале телеведущий и доктор Александр Мясников рассказал, как вирусы вызывают онкологию. По его словам, связь между инфекцией в организме и последующим развитием рака прямая и очевидная.